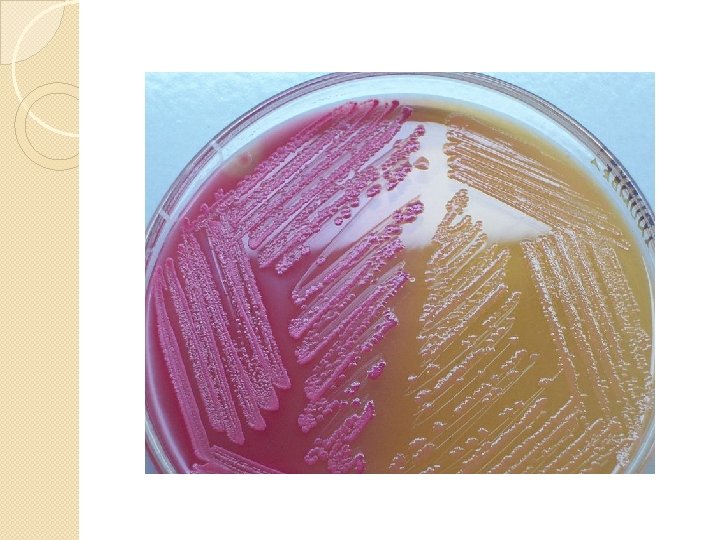
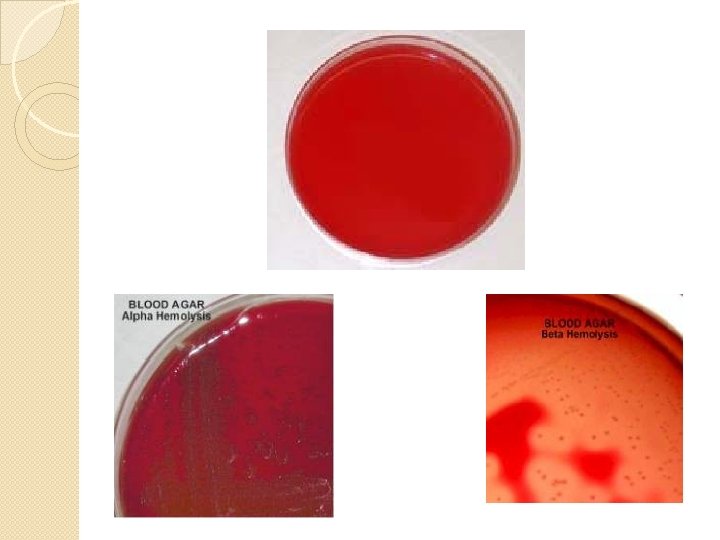
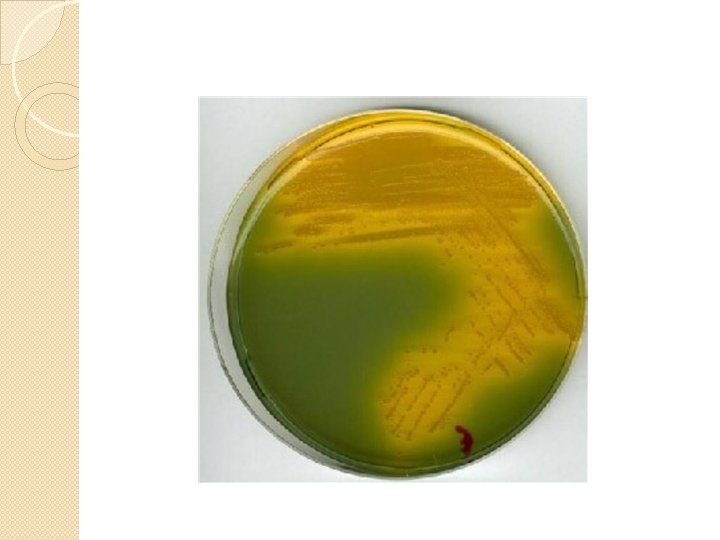
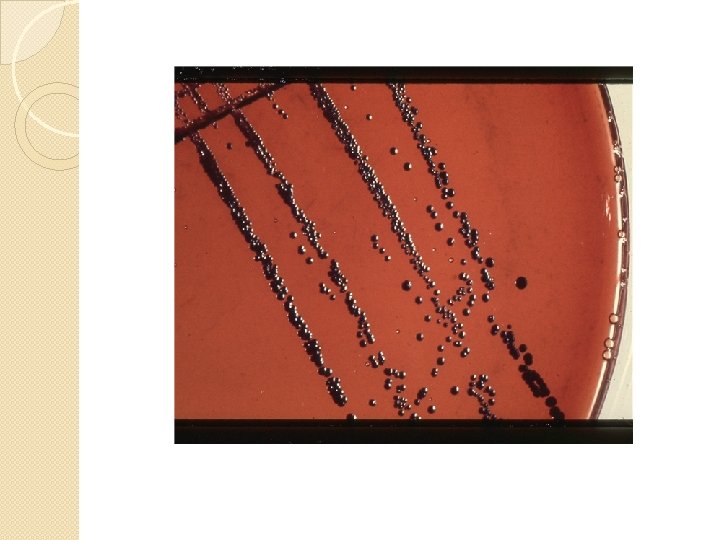

CULTURE MEDIA Required to grow the microorganisms to

- Slides: 36
CULTURE MEDIA • Required to grow the micro-organisms to identify them. Basic constituents: 1. Water. 2. Electrolyte. 3. Peptone. 4. Meat extract. 5. Blood or serum. 6. Agar.
CLASSIFICATION 1. Based on physical state: a. Liquid media. b. Semisolid media. c. Solid media.
Fannie
2. Based on composition: a. Defined media. b. Complex media.
3. Based on nutritional factors: 1. Simple media A. Peptone water: � Ingredients : Peptone, Na. Cl, distilled water � p. H : 7. 4 – 7. 5 � Sterilization : Autoclaving at 121 °C for 15 min, Uses: � 1. To grow non- fastidious bacteria. � 2. Used as a base for carbohydrate fermentation. � 3. Used to test for indole production. � 4. For bacterial subculture.
B. Nutrient agar: Ingredients : Peptone, Na. Cl, meat extract, 2% agar, distilled water p. H : 7. 4 – 7. 5 Sterilization : Autoclaving at 121°C for 15 min. Uses : 1. To grow non-fastidious bacteria for � a) Isolation of bacteria � b) Studying colony morphology � c) Antibody susceptibility testing 2) Can be prepared in the form of plates, slopes and butts for storage of pure growth of aerobic cultures.
2. Enriched media: A. Blood agar: � Ingredient : Nutrient agar base, sheep blood 5 – 10 % � p. H : 7. 4 – 7. 5 � Preparation : Autoclave nutrient agar add sheep blood at 50°C , cool and pour into plates. Uses : 1) Used especially to grow fastidious bacteria such as Streptococcus pyogenes. 2) To demonstrate hemolysis ( α , β, γ ) 3) Used for anaerobic cultures by adding certain supplements
B. Chocolate agar: �Ingredients : Nutrient agar, Sheep Blood (5 - 10%) �p. H : 7. 4 – 7. 5 �Preparation : Autoclaving basal media and adding sheep blood at temperatures of 75 – 80 50°C agitating till color changes to chocolate before pouring it to sterile plates. �Uses : To grow fastidious bacteria such as Hemophilia influenzae, which require X and V factors.
C. Loefflers’s serum slope: �p. H : 7. 6 �Sterilization : Inspissation �Ingredients : Sterile sheep serum, Nutrient agar and glucose. �Uses : To isolate Corynebacterium diphtheriae.
D. Dorset egg medium: �Ingredients : Basal media, egg albumin �Sterilization : Inspissation �Uses : Solid media for culturing Mycobacterium tuberculosis.
E. Milk agar: �p. H : 7. 6 �Sterilization : Inspissation �Ingredients : Fresh sterilized milk, nutrient agar base. �Uses : Used to detect pigmentation.
3. Differential and selective medium: A. Mac. Conkey’s agar: �Ingredients : Peptone, Sodium taurocholate, lactose, agar 2% �Indicator : Neutral red �p. H : 7. 4 to 7. 5 �Sterilization : Autoclaving at 121 °C for 15 min �Uses : 1. To isolate enterobacteria. 2. To differentiate between lactose fermenting and non-lactose fermenting enterobacteria.
B. Blood agar: � Ingredient : Nutrient agar base, sheep blood 5 – 10 % � p. H : 7. 4 – 7. 5 � Preparation : Autoclave nutrient agar add sheep blood at 50°C , cool and pour into plates. Uses : 1) Used especially to grow fastidious bacteria such as Streptococcus pyogenes. 2) To demonstrate hemolysis ( α , β, γ ) 3) Used for anaerobic cultures by adding certain supplements
SELLECTIVE MEDIA B. Wilson and Blair’s medium: �Ingredients : Bismuth sulphite phosphate mixture, iron – citrate, brilliant green , nutrient agar. �p. H : 7. 7 �Sterilization : To melted sterile nutrient agar add the other ingredients �and heat at 100 °C. Uses : 1. Isolation and preliminary identification of Salmonella typhi and other Salmonellae from clinical materials, sewage, water supplies
C. TCBS agar: �Ingredients : Peptone, yeast extract, Na. Cl, sodium thiosulfate, bile, ferric citrate, sodium citrate, Sucrose and bromothymol blue. �PH : 8. 6 �Sterilization : Heat the ingredients at 100 °C. Uses : Isolation of Vibrio cholerae the causative agent of cholera and other Vibrios from clinical materials.
D. Potassium tellurite agar: Ingredients : Sodium hydrogen selenite, peptone, lactose, di sodium hydrogen phosphate, distilled water Indicator : Potassium tellurite �p. H : 7. 6 �Sterilization : Agar base is autoclaved at 121°C for 15 minutes. �Uses : 1) For culture of Corynebacterium diphtheriae,
E. Lowenstein Jensen Media: �Ingredients : Egg fluid, glycerol, mineral salts solution , malachite green. �PH : 8. 6 �Sterilization : Heat the ingredients at 100 °C. �Uses : For primary isolation of Mycobacterium tuberculosis
4. Enrichment media: A. Alkaline peptone water: �Ingredients : Peptone, Na. Cl, Distilled water �p. H : 8. 6 �Sterilization : Autoclaving at 121°C for 15 min �Uses : Used for the enrichment of Vibrio cholera.
B. Bile broth: �Ingredients : Peptone, Na. Cl, Distilled water �p. H : 8. 6 �Sterilization : Autoclaving at 121°C for 15 min �Uses : 1. For blood culture of patients suffering from typhoid.
5. Sugar media :
6. Anaerobic culture media : Robertson's Cooked Meat Broth: �Ingredients : Heart tissue granules, proteose peptone, dextrose, �Na. Cl �PH : 7. 2 �Sterilization : Autoclaving at 15 lbs pressure (121°C) for 15 minutes. �Uses : 1) To grow anaerobes such as Clostridium sps
Mc. Intosh filde’s Anaerobic jar
Thank you